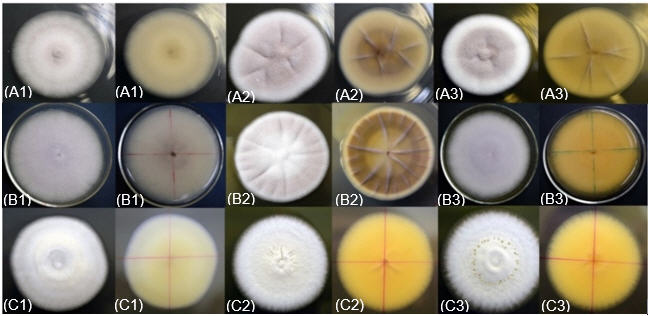
Características
macroscópicas de los aislados del género Cordyceps
(A), Purpureocillium (B)
y Beauveria
(C) en PDA (1), SDA (2) y MDA (3) en el adverso y reverso de los medios de
cultivo.

Biotecnología
Caracterización morfofisiológica y molecular de hongos entomopatógenos asociados a Hypothenemus hampei en áreas cafetaleras de la comarca Ngäbe-Buglè
Morphophysiological and molecular characterization of entomopatogenic fungi associated with Hypothenemus hampei in coffee areas of the Ngäbe-Buglè region
La Calera
Universidad Nacional Agraria, Nicaragua
ISSN: 1998-7846
ISSN-e: 1998-8850
Periodicidad: Semestral
vol. 21, núm. 36, 2021
Recepción: 08 Enero 2021
Aprobación: 10 Mayo 2021

Resumen: La broca del café, Hypothenemus hampei (Ferrari) (Coleoptera: Curculionidae: Scolytinae) es la principal plaga del cultivo del café (Coffea spp.) y colonizó recientemente este cultivo en la comarca Ngäbe-Buglè. Una de las alternativas de manejo de esta plaga es a través de sus enemigos naturales, por lo que el objetivo de este estudio fue caracterizar morfofisiológica y molecularmente aislados de hongos entomopatógenos nativos, colectados en la comarca Ngäbe-Buglè y seleccionar los más promisorios, para su inclusión en programas de manejo agroecológico de plagas. La identificación molecular se hizo mediante la secuenciación de la región del espaciador transcrito interno (ITS, del inglés Internal Transcribed Spacer) (ITS 1 y 2 incluyendo 5.8 S). Se identificaron 13 aislados pertenecientes a Beauveria bassiana (Vullevein), y un aislado de Purpureocillium lilacinum (Thom) Luangsa-ard, Hou- braken, Hywel-Jones & Samson. Adicionalmente, se incluyó un aislado (RS-Ij006) de Isaria javanica (= Cordyceps javanica (Frieder. & Bally) Samson & Hywel-Jones) de la colección de hongos entomopatógenos del Laboratorio de Entomología del IDIAP, David, para la determinación de las características morfológicas. Para la determinación de las características morfológicas se utilizaron tres medios de cultivo: Papa-Dextrosa-Agar, Malta-Dextrosa Agar y Sabouraud-Dextrosa-Agar. Se evaluó la mortalidad y se obtuvo el Tiempo Letal Medio (TL50)). Los mayores porcentajes de mortalidad de H. hampei, al día 15 después de la inoculación, se observaron con los aislamientos RS-Ij006 y D-Bb1400 con 100 %; seguidos por D-Bb1398 con 98.90 % y D-Bb1350 con 93.3 %. Los menores registros del TL50 se obtuvieron con los aislados de D-1388 (Purpureocillium lilacinum) con 3.52 días y RS-Ij006 con 3.98 días, seguidos por D-Bb1350 con 6.58 días. Los aislados a los que el insecto presentó menor susceptibilidad fueron D-1391, D-1399, D-Bb1397, D-Bb1412 y D-Bb1395, D-Bb1392, estos necesitaron más tiempo para alcanzar el 100 % de mortalidad de adultos de H. hampei y el TL50 fue superior a 11 días.
Palabras clave: Purpureocillium lilacinum, Cordyceps, Beauveria, manejo agroecológico, biodiversidad funcional.
Abstract: The coffee berry borer, Hypothenemus hampei (Ferrari) (Coleoptera: Curculionidae: Scolytinae) is a monophagous specie of coffee berries (Coffea spp.) and is one of the main pests of this crop in the Ngäbe-Buglè Region. The use of native natural enemies is one of the alternatives for managing this pest, because of that the objective of this study was to characterize morphologically, physiologically, and molecularly, isolated entomopathogenic fungi collected in coffee plantations of the Ngäbe-Buglè Region, to select those with potential, for inclusion in agroecological pest management programs. The molecular characterization of the isolates was performed by sequencing the ITS (Internal Transcribed Spacer) region (ITS 1 and 2 including 5.8 S) and comparison with the database GenBank. Twelve isolates were determined as belonging to Beauveria bassiana (Vullevein), and one isolate as Purpureocillium lilacinum (Thom) Luangsa-ard, Hou- braken, Hywel-Jones & Samson. Additionally, an Isaria javanica isolate (=Cordyceps javanica (Frieder. & Bally) Samson & Hywel-Jones)) from the entomopathogenic fungi collection of the Entomology Laboratory of IDIAP, David, was included for determination of morphological characteristics. Mortality and median lethal time were evaluated. The highest mortality rates, at day 15 after inoculation, were observed with RS-Ij006 and D-Bb1400 isolates with 100 %; followed by D-Bb1398 with 98.90 % and D-Bb1350) with 93.3 %. The least mean lethal times (TL50) were obtained with the isolates of D-1388 (Purpureocillium lilacinum) with 3.52 days and RS-Ij006 with 3.98 days followed by D-Bb1350 with 6.58 days. The isolates in which the insect presented lower susceptibility were D-1391; D-1399; D-Bb1397; D-Bb1412; D-Bb1395, D-Bb1392 these needed more time to reach 100 % adult mortality of H. hampei and the TL50 was greater than 11 days.
Keywords: Purpureocillium lilacinum, Cordyceps, Beauveria, agroecology, functional biodiversity.
El cultivo de café es de gran relevancia para la agricultura indígena y campesina familiar de la comarca Ngäbe-Buglè (CNB) debido a que representa el cuatro por ciento de la producción nacional, está entre los tres cultivos de mayor importancia económica para la población local, en cuanto a número de explotaciones y generación de ingresos como lo señala el Instituto Nacional de Estadística y Censo (2011). Además, por las características del manejo del cultivo en agroecosistemas forestales, ofrece una gama importante de servicios ambientales como son: captura de agua, conservación del suelo, captura de carbono, así como la conservación y protección de diversos grupos biológicos como son, principalmente, plantas (árboles, epífitas, etc.), aves, insectos y anfibios (Motta-Delgado y Murcia-Ordoñez, 2011).
La broca del café, Hypothenemus hampei (Ferrari) (Coleoptera: Curculionidae: Scolytinae) es una especie monófaga del fruto del café (Coffea spp.), que se considera la principal plaga insectil de este cultivo a nivel mundial (Monzón, 2001; Vázquez, 2005). En Panamá fue reportada por primera vez en la región occidental en el año 2005 (Castillo et al., 2013), con dispersión posterior hacia el resto de las zonas cafetaleras, y es en la actualidad una de las principales plagas de este cultivo en la comarca Ngäbe-Buglè (CNB), alcanzando infestaciones hasta de 29 % (Palacio et al., 2014).
Durante los primeros años de incidencia de esta plaga en Panamá, su manejo se basó principalmente en el uso de insecticidas, muchos de ellos altamente tóxicos y contaminantes al ambiente, principalmente por desconocimiento de otras alternativas de manejo de la plaga. González et al. (2018), reportan los hongos entomopatógenos (HEP) como enemigos naturales presentes en las poblaciones de H. hampei en la CNB. La aparición de epizootias en poblaciones de insectos se indica como un fenómeno natural (Monzón, 2007), que se propicia por diversos factores, principalmente las características propias del insecto hospedero, del patógeno y del ambiente, interactuando entre sí, además del efecto del manejo que se realiza en el sistema de producción (Vásquez, 2005). Entre las características de los HEP, se destacan la mortalidad total, el Tiempo Letal Medio (TL50), la velocidad de crecimiento diario (mm día-1), Tiempo Medio de Germinación o esporulación (TG50), entre otras (Carrillo-Rayas y Blanco-Labra, 2009; Lezcano et al., 2015).
Los HEP pertenecen a un amplio grupo de microorganismos que proveen múltiples servicios a los agroecosistemas, como la regulación biótica, la estabilidad del suelo, la descomposición de la materia orgánica, entre otros (Sarandón, 2020). Motta-Delgado y Murcia-Ordóñez (2011) indican que los HEP de mayor utilización para el control biológico incluyen a: Metarhizium, Beauveria, Aschersonia, Entomophora, Zoophthora, Erynia, Eryniopsis, Akanthomyces, Fusarium, Hirsutella, Hymenostilbe, Paecilomyces y Lecanicillium (Verticillium). De los cuales los de mayor utilización en el mundo son M. anisopliae, B. bassiana, B. brongniartii, P. fumosoroseus (Isaria fumosoroseus) (Téllez-Jurado et al., 2009).
Debido al potencial de las epizootias causadas por HEP en la broca del café, se propuso realizar análisis morfofisiológicos y moleculares de los hongos entomopatógenos encontrados naturalmente asociados a H. hampei (Ferrari), como primer paso en el desarrollo de la alternativa de su uso como agentes de control biológico de la plaga. Así, el objetivo de este estudio fue caracterizar morfofisiológica y molecularmente los aislados de HEP colectados en la CNB afectando naturalmente poblaciones de H. hampei (Ferrari), y seleccionar las que muestren mejor potencial patogénico para su incorporación en programas de manejo agroecológico de dicha plaga.
MATERIALES Y MÉTODOS
Colecta purificación y aislamiento
Se colectaron cadáveres de H. hampei con crecimiento micelial, en una plantación de café de la localidad de Cerro Tula (8°24´18.17´´ y 81°47´5.51´´; corregimiento de Hato Chamí, distrito de Nolé Duima en la CNB, los que fueron desinfectados superficialmente en el laboratorio de Entomología del Instituto de Innovación Agropecuaria de Panamá (IDIAP) en David, Provincia de Chiriquí, con hipoclorito de sodio al 0.5% durante cinco minutos, y lavados con agua destilada estéril. Seguidamente, estos se colocaron individualmente en cámara húmeda (90 % HR y 25±1°C). Los hongos que se desarrollaron en los cadáveres fueron aislados y sembrados en medio de cultivo Papa Dextrosa Agar (PDA), y codificados. Para fines de comparación, se incluyó en el estudio, el aislado RS-Ij006 (Cordyceps javanica) procedente de la colección de hongos entomopatógenos del IDIAP Centro de Innovación Agropecuaria Chiriquí, David, Chiriquí.
Caracterización molecular
Identificación molecular a través de genes de ADNr. La extracción del ADN genómico de los aislados obtenidos, se realizó en el Laboratorio de Biología Molecular del Instituto de Investigaciones Científicas y Servicios de Alta Tecnología (INDICASAT), Ciudad del Saber, Panamá. Se empleó un kit de purificación de ADN de QuiaGen®. La amplificación del fragmento de ITS por PCR se realizó con los cebadores (primers) ITS5 (5’-GGA AGT AAA AGT CGT AAC AAG-3’) e ITS4 (5’-TCC TCC GCT TAT TGA TAT GC-3’), usando 30 ciclos de desnaturalización (94 °C por 45 s), hibridación (55 °C por un minuto) y polimerización (72 °C por 45 s). Los cebadores se diseñaron de las secuencias conservadas 18S-ADNr y 28S-ADNr en hongos. Las secuencias de nucleótidos de los fragmentos amplificados se compararon con las secuencias ya publicadas en la base de datos del NCBI (National Center for Biotechnology Information). A las secuencias de ADN obtenidas, se agregó una (RSCj006), previamente identificada, obtenida a partir de Trialeurodes vaporariorum (González et al., 2015). Las distancias evolutivas se calcularon utilizando el método de la distancia p (Nei y Kumar, 2000) y se muestran en las unidades del número de diferencias de base por sitio. Este análisis involucró 18 secuencias de nucleótidos. Todas las posiciones ambiguas se eliminaron para cada par de secuencias (opción de eliminación por pares). Hubo un total de 751 posiciones en el conjunto de datos final. Los análisis evolutivos se realizaron en MEGA X (Kumar et al., 2018).
Caracterización morfofisiológica
Características macroscópicas. Los hongos se identificaron morfológicamente a nivel de especie (Seifert et al., 2011). Se obtuvieron cultivos monospóricos a partir de colonias puras de los aislados en medio de cultivos PDA (Leucona, 1996). A partir de los cultivos monospóricos, los aislados se sembraron en PDA, Malta Dextrosa Agar (MDA) y SDA (Sabourad Dextrosa Agar). La siembra se hizo, colocando en el centro de los platos petri, un trozo del cultivo monospórico y se incubaron a 26±1°C en oscuridad. Para cada aislado se utilizaron cinco réplicas por cada medio de cultivo. A los 10 días de sembrado (dds), se registraron las características macroscópicas como forma de la colonia, elevación, aspecto de la superficie y color del micelio. La coloración por el anverso y el reverso de las colonias se estimó siguiendo los códigos de la paleta de color de suelos Munsell (Munsell Color Company, 2000).
Crecimiento radial. Para determinar el crecimiento radial, se colocó un cultivo monospórico en el centro del plato con medio de cultivo y se colocó en incubación a 26±1°C en oscuridad. Para fines de realizar las mediciones de crecimiento, en la parte posterior de los platos se marcaron cuatro radios, sobre los que se hicieron las mediciones, las que se realizaron durante 10 días, iniciando al segundo día después del establecimiento del ensayo. Con los datos obtenidos se determinó la tasa de crecimiento en mm día-1 (French y Hebert, 1982) para los tres medios de cultivo.
Diámetro de la colonia. A partir de cultivos monospóricos incubados a 26±1°C por 10 días; se midió el diámetro (mm) en dos puntos de la colonia, realizando dos lecturas por cada plato petri.
Características microscópicas
Tamaño de conidias. Se obtuvo conidias a partir de un cultivo puro de 10 dds, de los hongos del estudio, y se midió el largo y ancho de las mismas, utilizando un microscopio óptico Olympus CX31 con un aumento de 100x. Se evaluaron 50 conidias por aislado y por medio de cultivo, para medir su tamaño en micras (French y Hebert, 1982).
Concentración de conidias. La concentración de conidias se midió a los 10 días, luego del crecimiento radial de las colonias. En tubos Falcon de 15 ml conteniendo 10 ml de Tween 80 al 0.05 % (v/v) se colocaron individualmente tres secciones de 1 cm diámetro del crecimiento esporulado de los aislados. Posteriormente se realizaron diluciones sucesivas hasta la dilución 10-3. Se realizaron cinco repeticiones por aislado. Se realizó el conteo al microscopio con la cámara de Neubaüer (Neubaüer improved, Marienfeld, Alemania) y se registraron los conteos de conidias producidas (cm2) por cada aislado en los tres medios de cultivo (French y Hebert, 1982).
Germinación
La capacidad germinativa de los aislados fue evaluada simultáneamente a la prueba de patogenicidad. Se utilizó una concentración de 1x106 conidias ml-1 y se colocaron alícuotas de 5 µl en siete puntos del medio en platos petri, se incubaron durante 24 horas a 26 °C y se adicionó una gota de azul de lactofenol con el fin de suspender el proceso de germinación y teñir las esporas. Se recortaron trozos del cultivo en los puntos de inoculación, se hicieron montajes en portaobjeto y se procedió al conteo de conidias germinadas y no germinadas en cinco campos microscópicos. La observación microscópica se realizó con un aumento de 40x; los resultados se expresaron en porcentaje de esporas germinadas. Para cada aislamiento se utilizaron cinco cajas de petri por repetición.
Mortalidad de H. hampei
Para evaluar la mortalidad y TL50 de los hongos aislados, se utilizaron adultos de aproximadamente 10 días, obtenidos de una cría de H. hampei, establecida a partir de adultos colectados de cerezas de café infestadas naturalmente. La inoculación se realizó por inmersión en una suspensión de 1 x 109 conidias ml-1 + Tween 80 (0.1%) durante un minuto. Como testigo se utilizó agua destilada estéril + Tween 80 (0.1%). La unidad experimental se estableció con 10 adultos de H. hampei, colocados individualmente en viales de vidrio, donde se les suministró un grano de café pergamino. El ensayo se mantuvo a 25±1°C, en cámara húmeda con agua destilada estéril sobre papel toalla esterilizado. La mortalidad se registró diariamente durante 15 días y los cadáveres se colocaron individualmente en cámara húmeda con el fin de obtener esporulación. El Tiempo Letal Medio fue calculado mediante el método de regresión lineal simple.
Análisis estadístico
Los datos del crecimiento lineal se transformaron a log (x + 1); este y la producción de conidias se analizaron mediante un análisis de varianza y separación de medias con Tukey (α = 0.05%). Los datos de mortalidad se transformaron a arcos(√x/100) y se analizaron mediante una prueba de Kruskal-Wallis (α = 0.05%).
RESULTADO Y DISCUSIÓN
Colecta, purificación y aislamiento
A partir de los especímenes de H. hampei, se obtuvieron 14 aislados de hongos, los que fueron codificados de la siguiente manera: D-Bb1350, D-Pl1388, D-Bb1391, D-Bb1392, D-Bb1395, D-Bb1397, D-Bb1398, D-Bb1399, D-Bb1400, D-Bb1401, D-Bb1402, D-Bb1405, D-Bb1406, D-Bb1412.
Caracterización molecular
Al analizar las secuencias, 13 de los 14 aislados correspondieron 100 % a Beauveria bassiana Bals. (Vuill.) (Accesiones MG548313.1 y MH922794.1). Un aislado se identificó como muy cercano al género Isaria (=Paecilomyces) similar al aislado RS-Ij006 y coincidió 100 % (Accesión KF624800.1) con el género Purpureocillium lilacinum del GenBank. Luangsa-ard et al. (2011), proponen este microorganismo como un nuevo género Purpureocillium y una nueva combinación Purpureocillium lilacinum para el anteriormente conocido como Paecilomyces lilacinus, especie que según Luangsa-ard et al. (2011) cuando es usado en altas concentraciones representa un riesgo para la salud en humanos inmuno-comprometidos. Por lo anterior, este material se debe manejar con reserva ya que se requieren realizar más investigaciones que determinen los factores de patogenicidad en humanos (Luangsa-ard et al., 2011). El aislado RS-Ij006 corresponde a Isaria javanica (Friedrichs y Bally) (Samson y Hywell-Jones (Luangsa-ard et al., 2011) y sus secuencias están depositadas en el GenBank con las accesiones KF373690 y KF373691 (González et al., 2015). Este género, se le ha reubicado recientemente con el nuevo nombre de Cordyceps en una revisión posterior por Kepler et al. (2017). El nuevo nombre de Isaria javanica se indica en lo sucesivo como Cordyceps javanica. Los análisis evolutivos filogenéticos y moleculares de las secuencias obtenidas dio como resultado el árbol filogenético reflejado en la Figura 1. Las relaciones evolutivas de taxones se infirieron mediante el método del vecino más cercano (Saitou y Nei, 1987). Se muestra el árbol óptimo con la suma de la longitud de la rama = 0.66904220. Se observó poca variabilidad entre los aislamientos de B. bassiana. El análisis separó los aislamientos de B. bassiana en un grupo y colocó el aislamiento D-1388 diferenciado de las accesiones Isaria (KF373690 y KF373691) y del aislamiento MK120858.1 Purpureocillium utilizado como grupo externo. Los números de accesión asignados en el GenBank, para cada secuencia de nucleótidos de los aislados analizados en este estudio fueron: MZ151175 (D-Bb1350); MZ151176 (D-Pl1388); MZ151177 (D-Bb1391); MZ151178 (D-Bb1392), MZ151179 (D-Bb1395), MZ151180 (D-Bb1397) MZ151181 (D-Bb1398), MZ151182 (D-Bb1399), MZ151183 (D-Bb1400), MZ151184 (D-Bb1401), MZ151185 (D-Bb1402), MZ151186 (D-Bb1405), MZ151187 (D-Bb1406), MZ151188 (D-Bb1412).
Con relación a la condición de aislados endémicos, por ser colectados afectando naturalmente poblaciones de H. hampei en la CNB, Rehner et al. (2006, p.18), en un amplio estudio filogenético de B. bassiana, establecieron que "la alta diversidad genética detectada en el ubicuo Neotropical AFNEO_1 geográfica y ecológicamente, sugiere que este linaje es endémico y está bien establecido en el Neotrópico".

Caracterización Morfofisiológica
Los hongos aislados se depositaron en la colección de hongos entomopatógenos del Laboratorio de Entomología del Centro de Investigación Agropecuaria de Chiriquí con una réplica en la colección de referencia de hongos entomopatógenos de la Estación Experimental del IDIAP en Río Sereno.
Características macroscópicas
Los aislados de los hongos entomopatógenos correspondieron a 12 aislamientos nativos de B. bassiana (D-Bb1350, D-Bb1391, D-Bb1392, D-Bb1395, D-Bb1397, D-Bb1398, D-Bb1399, D-Bb1400, D-Bb11402, D-Bb1405, D-Bb1406, D-Bb1412) y un aislamiento nativo D-1388, correspondiente a Purpureocillium lilacinum.
La forma, el borde y el color de las colonias resultaron comunes a todos los aislados de B. bassiana. Todos presentaron colonias circulares, borde liso y color blanco (Gley 8/N según tabla Munsell) por el anverso (Figura 2). En cuanto a la elevación, se distribuyeron en tres tipos, desde plana a convexa, con situaciones intermedias referidas a la altura de los bordes y al tamaño de la elevación central. El aislado D-Bb1397 mostró ser variable en cuanto a la elevación ya que algunas colonias formaron anillos más elevados y otras, depresión central con crecimiento de altura irregular (e.g. D-Bb1397). En cuanto al aspecto de la superficie, la mayor parte de las colonias no presentaron irregularidades y sólo algunas (D-Bb1391, D-Bb1402, D-Bb1405) produjeron anillos concéntricos.
La apariencia de los aislados de B. bassiana, por el anverso y el reverso de las colonias mostraron características culturales similares en los tres medios evaluados. Los materiales correspondientes a B. bassiana presentaron un aspecto inicial algodonoso para luego convertirse pulvurulento y superficie semi-elevada, coincidiendo con lo descrito para el género Beauveria por Vélez et al. (2001), y por Rodríguez y Del Pozo (2003).
En el reverso, el crecimiento micelial de B. bassiana fue tomando un color amarillento claro que fue más fuerte (5Y 8/5) en el medio MDA, intensidad media (5Y 8/6), en el SDA y más pálido en el medio PDA (2.5Y 7/8). Adicionalmente se observó la formación de radios en el medio de SDA ligeramente marcados en algunos aislados de B. bassiana (D-Bb1350, D-Bb1398, D-Bb1399, D-Bb1405, D-Bb1406, D-Bb1412).
Las características morfológicas de los aislados de Beauveria, correspondieron a lo reportado por Glare e Inwood (1998). Mientras que el color de los aislados de D-Pl1388 (Purpureocillium) en el lado anverso es rosáceo liláceo (10R 7/2), en contraste con el aislado RS-Cj006 (Cordyceps) que fue rosado pálido (10R 5/2); de aspecto friable y superficie plana, crecimiento concéntrico con cambio en la coloración diaria; inicialmente blanca para tornarse rosáceo pálido en 24 horas. Adicionalmente se observó la formación de radios muy marcados en el medio de SDA tanto en el anverso como en el reverso en los aislados D-Pl1388 (Purpureocillium), RS-Cj006 (Cordyceps) y muy atenuados en el reverso de Beauveria (Figura 2). Similarmente en el medio MDA, se presentó la formación de radios menos acentuada en el aislado RS-Cj006 (Cordyceps). La coloración por el reverso según tabla Munsell fueron para RS-Cj006 (Cordyceps): 5Y 8/2 en medio PDA, 10YR 6/2 en medio SDA, y 10YR 5/4 en MDA; y para D-Pl1388 (Purpureocillium): 5Y 8/2 en PDA, 10YR 5/8 en SDA, y 10YR 4/6 en MDA
Crecimiento lineal
Los aislamientos D-Pl1388 y el RS-Ij006 mostraron un crecimiento significativamente (p< 0.0001) mayor que los aislados de B. bassiana. El aislado D-Pl1388 fue el que presentó mayor crecimiento con 4.53 mm día-1 seguida por la RS-Ij06 con 1.93 mm día-1, mientras que los valores obtenidos por los aislados de B. bassiana estuvieron en el rango 1.1 a 1.62 mm día-1 (Cuadro 1). El crecimiento lineal es un indicativo de la habilidad del hongo para invadir los sustratos donde crece (Montesinos-Matías et al., 2011), por lo que esta capacidad competitiva se puede considerar una característica deseable.
| Aislado | Diámetro de la colonia (mm)1/ | Crecimiento radial (mm día-1)2/ | ||
| D-Pl1388 | 87.97 | a | 4.53 | a |
| RS-Ij006 | 42.05 | b | 1.93 | b |
| D-Bb1392 | 32.05 | c | 1.10 | f |
| D-Bb1397 | 31.66 | cd | 1.54 | f |
| D-Bb1400 | 31.62 | cd | 1.23 | f |
| D-Bb1391 | 31.33 | cde | 1.43 | f |
| D-Bb1402 | 30.66 | cdef | 1.52 | f |
| D-Bb1399 | 30.52 | cdef | 1.61 | f |
| D-Bb1398 | 30.43 | cdef | 1.54 | f |
| D-Bb1406 | 29.46 | cdef | 1.51 | f |
| D-Bb1395 | 29.23 | def | 1.51 | ef |
| D-Bb1350 | 28.42 | fg | 1.62 | cde |
| D-Bb1412 | 26.41 | gh | 1.57 | c |
| D-Bb1405 | 25.57 | h | 1.47 | cd |
| 1/CV = 32.73 % | 2/CV = 8.17 % | |||
El diámetro de las colonias de los aislados de B. bassiana en SDA osciló entre 21.98 mm y 32.1 mm, con un promedio de crecimiento de 27.8 mm. El crecimiento lineal promedio de B. bassiana fue de 1.49 mm día-1, mientras que para RS-Ij006 (Cordyceps javanica) fue de 1.93 mm día-1 y 4.53 mm día-1 para el aislado D-Pl1388 (P. lilacilum) (Cuadro 3). Estos resultados son similares a los reportados por Elósegui et al. (2003), quienes encontraron para B. bassiana, diámetros de la colonia que oscilaron entre 25 mm y 31 mm, y promedios de crecimiento lineal de 1.56 mm a 1.93 mm. De acuerdo con Mugnai et al. (1989), la edad del cultivo y sustrato de crecimiento determinan en gran medida las características morfológicas de los aislados. También se ha reportado que el desbalance entre las fuentes carbonatadas y nitrogenadas es el principal factor que afecta el crecimiento del hongo (Elósegui et al., 2003). Así, cuando las fuentes que aportan nitrógeno (N) en el medio (ejemplo el extracto de levadura) están dos o más veces concentradas con respecto a la fuente carbonatada (ejemplo la dextrosa), se estimula el crecimiento micelial (Jenkins y Prior, 1993).
La mayor capacidad potencial de dispersión se observó en el género Purpureocillium con el mayor promedio (p<0.001), de 4.1 mm día-1 (Figura 3b), seguido por Cordyceps con 2.12 mm día-1, mientras que los aislados de Beauveria tuvieron el menor promedio de crecimiento lineal con 1.49 mm día-1. Estas diferencias (p<0.0001), también se observaron al comparar por género el diámetro de la colonia al décimo día de crecimiento (Figura 3a), se observaron diferencias significativas destacándose el género Purpureocillium con 87.97 mm, seguido por el género Cordyceps con 42.05 mm y Beauveria con 29.7 mm.

Características microscópicas
Tamaño y forma de conidias. Las conidias de los 12 aislados son lisas, globosas a ovoides; de acuerdo con esta forma, tamaño, así como también al raquis en forma de “zigzag”, fueron caracterizadas morfológicamente pertenecientes a la especie B. bassiana (Figura 4).

En el Cuadro 2 se observa que el tamaño de las conidias osciló en 1.2-3.0 x 1.0-2.8 µm. Este tamaño es reportado por diversos autores para B. bassiana (Kepler et al., 2017; Glare e Inwood 1998), quienes, luego de comparar diversas cepas de especies de Beauveria, provenientes de diferentes países, concluyeron que las cepas con conidias esféricas y menores de 3 µm de diámetro pueden ser consideradas como B. bassiana (French y Hebert, 1982; Glare e Inwood, 1998, Vélez et al., 2001; Kepler et al., 2017).
Para el aislado D-1388 la variación fue de 4.1-10.2 x 1.1-3.8 µm. y para el RS-Ij006 de 4.8-6.2 x 1.1-1.6 µm; ambas de forma fusoides alargadas. Inicialmente por la forma de las conidias, se encontró coincidencia con lo descrito para el género Cordyceps (=Isaria), sin embargo, el aspecto de la colonia difería con el del aislado RS-Ij006. En la Cuadro 3 se observan los promedios del largo y ancho de las esporas para cada uno de los aislados.
| Aislados | Largo (µm) | Ancho (µm) | Promedio largo | Promedio ancho | |||
| Mínimo | Máximo | Mínimo | Máximo | Mínimo (µm) | Máximo (µm) | ||
| RS-Ij006 | 4.8 | 6.2 | 1.1 | 1.6 | 5.46 | 1.33 | |
| D-Pl1388 | 4.1 | 10.2 | 1.1 | 3.8 | 6.94 | 2.52 | |
| D-Bb1350 | 1.7 | 2.8 | 1.5 | 2.7 | 2.24 | 2.07 | |
| D-Bb1391 | 1.7 | 2.8 | 1.5 | 2.6 | 2.23 | 2.07 | |
| D-Bb1392 | 1.6 | 2.8 | 1.4 | 2.6 | 2.26 | 2.09 | |
| D-Bb1395 | 1.9 | 2.8 | 1.7 | 2.6 | 2.20 | 2.03 | |
| D-Bb1397 | 1.7 | 2.6 | 1.5 | 2.4 | 2.23 | 2.05 | |
| D-Bb1398 | 1.7 | 2.8 | 1.5 | 2.6 | 2.24 | 2.07 | |
| D-Bb1399 | 1.7 | 2.7 | 1.6 | 2.5 | 2.19 | 2.03 | |
| D-Bb1400 | 1.8 | 2.8 | 1.6 | 2.6 | 2.20 | 2.04 | |
| D-Bb1402 | 1.7 | 2.8 | 1.5 | 2.6 | 2.22 | 2.03 | |
| D-Bb1405 | 1.7 | 2.7 | 1.5 | 2.5 | 2.18 | 2.01 | |
| D-Bb1406 | 1.7 | 2.6 | 1.5 | 2.4 | 2.17 | 2.00 | |
| D-Bb1412 | 1.9 | 2.7 | 1.7 | 2.5 | 2.19 | 2.03 | |
Con respecto al género (Cuadro 3), se observaron diferencias significativas entre los tres géneros estudiados (p<0.001) para las variables ancho y largo de conidias; siendo Purpureocillium el género que presentó el mayor largo (6.94 µm), seguido por Cordyceps con 5.46 µm y Beauveria con 2.21µm.
| Género | Promedio dimensiones (µm) | |
| Largo | Ancho | |
| Cordyceps | 5.46 a | 1.33 a |
| Purpureocillium | 6.94 b | 2.54 b |
| Beauveria | 2.21 c | 2.04 c |
Concentración de conidias
Los promedios de las concentraciones de conidias de los aislados del género Beauveria variaron de 10.46 a 11.13 x 1012 conidios cm-2 sin ser estadísticamente diferentes entre sí (p>0.05), siendo los aislados D-Bb1397 y el D-Bb1392 los que presentaron el mayor promedio, con 11.13x1012 cm-2 y el aislado D-Bb1395 con menor promedio de 10.46 x 1012 cm-2 (Cuadro 4). Estos valores fueron superiores a los observados para los géneros Cordyceps y Purpureocillium.
| Aislado | Concentración promedio (cm-2) | Medio de cultivo | ||
| PDA | MDA | SDA | ||
| D-Bb1397 | 11.13 a | 9.68 | 10.16 | 13.56 |
| D-Bb1392 | 11.13 a | 9.22 | 10.50 | 13.67 |
| D-Bb1399 | 10.94 a | 9.66 | 9.66 | 13.50 |
| D-Bb1391 | 10.90 a | 9.59 | 9.87 | 13.25 |
| D-Bb1350 | 10.87 a | 9.44 | 9.53 | 13.64 |
| D-Bb1412 | 10.83 a | 9.43 | 9.51 | 13.56 |
| D-Bb1402 | 10.76 a | 8.62 | 10.24 | 13.41 |
| D-Bb1405 | 10.75 a | 9.13 | 9.59 | 13.53 |
| D-Bb1406 | 10.74 a | 9.15 | 9.49 | 13.59 |
| D-Bb1398 | 10.67 a | 9.06 | 9.54 | 13.41 |
| D-Bb1400 | 10.67 a | 9.15 | 9.79 | 13.07 |
| D-Bb1395 | 10.46 a | 8.06 | 9.76 | 13.56 |
| RS-Ij006 | 2.27 b | 1.01 | 1.99 | 3.80 |
| D-Pl1388 | 1.63 b | 1.32 | 1.63 | 1.93 |
El género Beauveria produjo significativamente (p<0.001) la mayor concentración de conidias (10.82 cm-2) seguido por Cordyceps (RS-Ij006) con 2.27 cm-2 y Purpureocillium (D-Pl1388) con promedio de 1.63 cm-2 sin ser los dos últimos diferentes entre sí (p> 0.05). La mayor concentración de conidias obtenida por los aislados de Beauveria, sugiere que esta característica ha sido desarrollada para compensar su relativo lento crecimiento radial.
| Género | Concentración (N° conidias cm-2) | Medio de cultivo | ||
| PDA | MDA | SDA | ||
| Beauveria | 10.82 a | 9.21 | 9.79 | 13.45 |
| Cordyceps | 2.27 b | 1.01 | 1.99 | 3.80 |
| Purpureocillium | 1.63 b | 1.32 | 1.63 | 1.93 |
| CV | 7.73 % | |||
Mortalidad de H. hampei
En 60 % de los aislados la mortalidad fue superior a 70 % (Cuadro 6). Con base en la mortalidad evaluada a los 15 días después de la inoculación, se determinó que los mejores tratamientos fueron RS-Ij006 y D-Bb1400, con 100 % de mortalidad, seguidos por D-Bb1398, con 98.9 %, indicando la presencia de aislamientos más eficaces que otros.
Al evaluar el TL50 se observó que los aislados D-Pl1388 y RS-Ij006 causaron el 50 % de mortalidad en menor tiempo, con 3.52 días y 3.98 días; seguidos por los aislados D-Bb1350 con 6.58 días; D-Bb1400 con 7.86 días y D-Bb1398 con 8.43 días. Los demás aislamientos requirieron de un tiempo de 11 días o más para eliminar el 50 % de la población (Cuadro 6).
Velocidad de germinación
Los aislamientos registraron un TG50 de entre 9.38 y 14.75 horas; siendo clasificados en tres grupos: TG50 corto, para los aislamientos RS-Ij006 y D-Pl1388 con 9.45 y 9.38; TG50 intermedio para D-Bb1400, D-Bb1402, D-Bb1405, D-Bb1398, D-Bb1350, que oscilaron entre 13.97 y 14.12 horas y TG50 largo para los demás, que oscilaron entre 14.68 a 14.75 horas. Según Shah et al. (2005), la velocidad de germinación es una de las determinantes de virulencia más reportadas. Los valores de TG50 que se reportan en este estudio son similares a los reportados por Díaz y Leucona (1995) con aislados de Beauveria colectados en diferentes regiones de Argentina, los que oscilaron entre 12h 10 min y 20h 4 min. Por otra parte, Montesinos-Matías et al. (2011), indican que, una germinación lenta hace a los HEP sean más sensibles a las variaciones ambientales, mientras que una rápida germinación les confiere mayor probabilidad de éxito en campo.
| Aislado | Mortalidad (% a los 15 días) | TL50 (días) | TG50 (horas) |
| RS-Cj006 | 100.00 | 3.98 | 9.45 |
| D-Pl1388 | 80.00 | 3.52 | 9.38 |
| D-Bb1350 | 93.30 | 6.58 | 14.12 |
| D-Bb1391 | 63.30 | 11.61 | 14.75 |
| D-Bb1392 | 40.00 | 17.29 | 14.72 |
| D-Bb1395 | 43.30 | 18.49 | 14.68 |
| D-Bb1397 | 53.30 | 15.05 | 14.71 |
| D-Bb1398 | 98.90 | 8.43 | 14.05 |
| D-Bb1399 | 66.70 | 11.93 | 14.74 |
| D-Bb1400 | 100.00 | 7.86 | 13.99 |
| D-Bb1402 | 86.70 | 11.38 | 14.01 |
| D-Bb1405 | 83.30 | 11.57 | 14.03 |
| D-Bb1406 | 70.00 | 11.73 | 14.68 |
| D-Bb1412 | 50.00 | 16.10 | 14.74 |
CONCLUSIONES
Se diferenciaron aislados nativos de hongos, mediante la caracterización morfofisiológica y molecular. Los aislados de B. bassiana D-Bb1400, D-Bb1350 y D-Bb1398, presentaron alto potencial patogénico para el control de H. hampei, alta producción de conidias y buen Tiempo de Germinación Medio por lo que pueden ser incorporados como parte de una estrategia de Manejo Agroecológico de la broca del café.
El conjunto de aislados de B. bassiana mostraron diferencias entre sí en cuanto a la mortalidad de H. hampei, no obstante, el análisis filogenético no muestra variación genética, ubicándolas en un mismo grupo. Esto abre perspectivas para estudios posteriores de búsqueda de marcadores moleculares específicos que distingan estas cepas correlacionándolas con su potencial de mortalidad.
Agradecimientos
Se agradece al Laboratorio de Investigaciones Botánicas-Herbario de la Escuela de Biología de la Universidad Autónoma de Chiriquí (UNACHI) y a la doctora Tina Hoffman por su apoyo en el procesamiento preliminar de los aislados obtenidos. Al INDICASAT y al doctor Luis Mejía y su equipo de trabajo, por su colaboración para el procesamiento de las secuencias. Se agradece al productor José Gallardo por compartir sus conocimientos, por la atención brindada y permitir la colecta de muestras en sus cafetales. A los revisores por sus valiosos aportes para mejorar el documento.
Referencias
Carrillo-Rayas, M. T., y Blanco-Labra, A. (2009). Potencial y algunos de los mecanismos de acción de los hongos entomopatógenos para el control de insectos plaga. Acta Universitaria, 19(2), 40-49. https://www.redalyc.org/pdf/416/41611810005.pdf
Castillo, S., Bernal, J. A., Lezcano, J., Piepenbring, M., y Cáceres, O. (2013). Hongos entomopatógenos asociados a insectos recolectados en plantaciones de café en el oeste de Panamá. Tecnociencia, 15(2), 29-39. https://revistasvip.up.ac.pa/index.php/tecnociencias/article/view/966/954
Diaz, B. M., y Lecuona, R. E. (1995). Evaluación de cepas nativas del hongo entomopatógeno Beauveria bassiana Bals (Vuill.) (Deuteromicotina) como base parala selección de bioinsecticidas contra el barrenador Diatraea saccharalis (F.). Agriscientia, (12), 33-38. https://revistas.unc.edu.ar/index.php/agris/article/view/2450/1396
Elósegui, O., Nieves, N., Raysa Díaz, R., Bel Padrón, N., y Carr, A. (2003). Comportamiento del hongo entomopatógeno Beauveria bassiana (Bals.) Vuill. cepa lbb-1 en Agar sabouraud dextrosa producido en Cuba. Fitosanidad, 7(2), 49-53.
French, E., y Hebert, T. (1982). Métodos de investigación fitopatológica. Instituto Interamericano de Cooperación para la Agricultura. http://orton.catie.ac.cr/repdoc/A8740e/A8740e.pdf
Glare, T. R., y Inwood, A. J. (1998). Morphological and genetic characterization of Beauveria spp. from New Zealand. Mycological Research, 102(2), 250-256.
González Dufau, G.I., Caballero, S., Contreras, G., Vergara, G., y Mejía, L. C. (2015). Caracterización morfológica y molecular del aislado endémico RS006, biocontrolador de Hypothenemus hampei en Panamá. Revista Ciencia Agropecuaria, (22), 78-85. http://www.revistacienciaagropecuaria.ac.pa/index.php/ciencia-agropecuaria/article/view/166/131
González-Dufau, G. I., Santamaría Guerra, J., Torres, L., Santo, U., y Sanjur, M. (2018). Manejo ecológico de la broca del café (Hypothenemus hampei) en Cerro Tula, comarca Ngäbe-Buglè, Panamá. Cadernos de Agroecología, 13(1). http://cadernos.aba-agroecologia.org.br/index.php/cadernos/article/view/1713/1125
Instituto Nacional de Estadística y Censo. (2011). VII Censo Nacional Agropecuario, 2011. Resultados Finales Básicos. https://www.inec.gob.pa/publicaciones/Default3.aspx?ID_PUBLICACION=364&ID_CATEGORIA=15&ID_SUBCATEGORIA=60
Jenkins, N. E., y Prior, C. (1993). Growth and formation of true conidia by Metarhizium flavoviride in a simple liquid medium. Mycological Research, 97(12), 1489-1494.
Kepler, R. M., Luangsa-ard, J. J., Hywel-Jones, N. L, Quandt, A., Sung, G. H., Stephen, A., y Shrestha, B. (2017). A phylogenetically-based nomenclature for Cordycipitaceae (Hypocreales). IMA FUNGUS, 8(2), 335-353. https://doi.org/10.5598/imafungus.2017.08.02.08
Kumar, S., Stecher, G., Li, M., Knyaz, C., y Tamura, K. (2018). MEGA X: Molecular Evolutionary Genetics Analysis across computing platforms. Molecular Biology and Evolution, 35(6), 547-1549. https://doi.org/10.1093/molbev/msy096
Leucona, R. E. (1996). Microorganismos patógenos empleados en el control microbiano de insectos plaga. Talleres Gráficos Mariano
Lezcano, J. A., Saldaña, E., Ruíz, R., y Caballero, S. (2015). Patogenicidad y virulencia del aislado de la cepa nativa de Isaria spp. y dos hongos entomopatógenos comerciales. Ciencia Agropecuaria, (23), 20-38. http://www.revistacienciaagropecuaria.ac.pa/index.php/ciencia-agropecuaria/article/view/120/85
Luangsa-ard, J., Houbraken, J., VanDoorn, T., Seung-Beom, H., Borman, A. M., Hywel-Jones, N. L., y Samson, R. A. (2011). Purpureocillium, a new genus for the medically important Paecilomyces lilacinum. FEMS Microbiol Letter, 321(2), 141–149. https://doi.org/10.1111/j.1574-6968.2011.02322.x
Montesinos-Matías, R., Viniegra-González, G., Alatorre-Rosa, R., Gallardo-Escamilla, F., y Loera, O. (2011). Variación de fenotipos de crecimiento y virulencia en cepas mutantes de Beauveria bassiana (Bals.) Vuill. Resistentes a 2-desoxi-d-glucosa. Agrociencia, 45(8), 929-942. http://www.scielo.org.mx/scielo.php?script=sci_arttext&pid=S1405-31952011000800006&lng=es&nrm=iso
Motta-Delgado, P. A., y Murcia-Ordoñez, B. (2011). Hongos entomopatógenos como alternativa para el control biológico de plagas. Ambiente y Agua an Interdisciplinary Journal of Applied Science, 6(2), 77-90. http://doi.org/10.4136/ambi-agua.187
Monzón, A. (2001). Producción, uso y control de calidad de hongos entomopatógenos en Nicaragua. Manejo Integrado de Plagas, (63), 95-103. http://www.bio-nica.info/biblioteca/Monzon2001HongoEntomopatogenos.pdf
Monzón, A. (2007). Insect pathogenic fungi in Hypothenemus hampei, and Leucoptera coffeella in the soil in coffee plantations in Central America: Natural occurrence, management system and genetic diversity [Tesis doctoral]. Norwegian University of Life Sciences.
Mugnai, L., Bridge, P. D., y Evans, C. A. (1989). A chemotaxonomic evaluation of the genus Beauveria. Mycological Research, 92(2), 199-209. https://doi.org/10.1016/S0953-7562(89)80012-7
Munsell Color (2000). Munsell soil color charts. Munsell color Baltimore.
Nei, M., y Kumar, S. (2000). Molecular Evolution and Phylogenetics. Oxford University Press
Palacio, E., Santamaría-Guerra, J., Torres, L., Sánchez, E., y González-Dufau, G.I. (2014). Manejo agroecológico de plagas y enfermedades del cultivo de café (Coffea arabica y Coffea canephora) en la comarca Ngäbe-Buglè. Informe Técnico Anual Plan Operativo Anual 2014. Instituto de Investigación Agropecuaria de Panamá.
Rehner, S. A., Posada, F., Buckley, E. P., Infante, F., Castillo, A., y Vega, F. (2006). Phylogenetic origins of African and neotropical Beauveria bassianas. l. pathogens of the coffee berry borer, Hypothenemus hampei. Journal of Invertebrate Pathology, 93(1), 11–21. https://doi.org/10.1016/j.jip.2006.04.005
Rodríguez Dos Santos, A., y Del Pozo, E. (2003). Aislamiento de hongos entomopatógenos en Uruguay y su virulencia sobre Trialeurodes vaporariorum West. Agrociencia, 7(2), 71-78. http://www.fagro.edu.uy/~agrociencia/index.php/directorio/article/view/374/293
Saitou, N., y Nei, M. (1987). The neighbor-joining method: A new method for reconstructing phylogenetic trees. Molecular Biology and Evolution, 4(4), 406-425. https://doi.org/10.1093/oxfordjournals.molbev.a040454
Sarandón, S. J. (2020). Biodiversidad, agroecología y agricultura sustentable. Editorial de la UNLP. http://sedici.unlp.edu.ar/bitstream/handle/10915/109141/Documento_completo.pdf-PDFA.pdf?sequence=1&isAllowed=y
Seifert, K., Morgan-Jones, G., Gams, W., y Kendrick, B. (2011). The Genera of Hyphomycetes. CBS-KNAW Fungal Biodiversity Centre; Utrecht, The Netherlands.
Shah, F. A., Wang, C. S., y Butt, T. M. (2005). Nutrition influences growth and virulence of the insect-pathogenic fungus Metarhizium anisopliae. FEMS Microbiol. Lett, 251(2), 259-266. https://doi.org/10.1016/j.femsle.2005.08.010
Téllez-Jurado, A., Cruz Ramírez, M. G., Mercado Flores, Y. A., Torres, A., y Arana-Cuenca, A. (2009). Mecanismos de acción y respuesta en la relación de hongos entomopatógenos e insectos. Revista mexicana de micología, (30), 73-80. http://www.scielo.org.mx/scielo.php?script=sci_arttext&pid=S0187-31802009000200007
Vázquez, L. L. (2005). Experiencia cubana en el manejo agroecológico de plagas en cafeto y avances en la broca del café [Presentación de paper]. Simposio sobre Situación Actual y Perspectivas de la Investigación y Manejo de la Broca del Café en Costa Rica, Cuba, Guatemala y México. México. https://www.researchgate.net/publication/286626732
Vélez, P., Estrada, A. N., González, M. T., Valderrama, A. M., y Bustillo, A. E. (2001). Caracterización de aislamientos de Beauveria bassiana para el control de la broca del café. Manejo Integrado de Plagas, (62), 38-53. http://www.sidalc.net/REPDOC/A2113E/A2113E.PDF
Notas de autor


